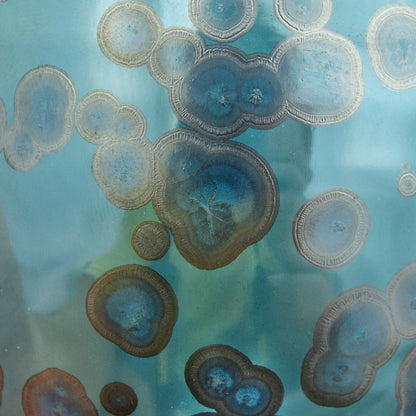
Szkliwo Krystaliczne  KJ  Forest Teal 476ml

Szkliwo Krystaliczne KJ Forest Teal 476ml
Stożek 8 – powolne chłodzenie
To szkliwo prezentuje subtelne, brązowe kryształy rozsiane na błyszczącym, głębokim odcieniu teal, tworząc delikatny kontrast i dyskretną elegancję. Szkliwo jest bardzo płynne.
Stożek 6
Więcej drobnych kryształów, mniejszy kontrast. Konsystencja półpłynna.
Wskazówka
Sprawdź tutorial dotyczący nakładania szkliw oraz techniki wypału z powolnym chłodzeniem.
Poniżej prezentujemy szybkie linki, w których znajdują się przydatne informacje. Jeśli jednak masz jakiekolwiek pytania odnośnie prowadzonych zajęć lub produktów prosimy o kontakt.
-
Informacje o towarach i wysyłkach
Wszystkie produkty wystawione w sklepie są dostępne stacjonarnie w naszej pracowni. Jeśli potrzebujesz więcej zdjęć lub informacji nie wahaj się do nas napisać. Paczki wysyłamy w przeciągu 48h a koszt transportu wyliczany jest w koszyku.
-
Obsługa klienta
Jesteśmy dostępni w dni powszednie od 13 do 19 jednakże skrzynka zarówno pocztowa jak i Instagram/Facebook są przez nas stale monitorowane i często zdarza się że odpowiadamy również poza wyznaczonymi godzinami.
-
Zapisy na zajęcia
Zapisy przyjmujemy wyłącznie przez naszą stronę lecz jeśli akurat nie ma miejsc w dogodnym dla Ciebie terminie - napisz do nas a zobaczymy co da się zrobić!
-
FAQ
Odpowiedzi na najczęściej zadawane pytania znajdziesz w specjalnie przygotowanym przez nas dziale FAQ tutaj.
-
Kontakt z nami
Udzielamy odpowiedzi zarówno poprzez email, czat na stronie, Instagram oraz Facebook. Prosimy jednakże nie wysyłać wiadomości SMS gdyż pozostaną one bez odpowiedzi.

